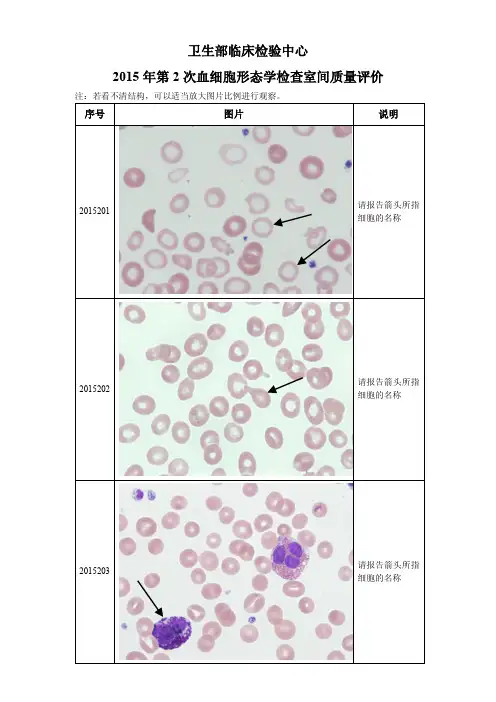

2007-2015年卫生部血细胞形态学检查室间质量评价
- 格式:pdf
- 大小:7.32 MB
- 文档页数:92

全国全血细胞计数室间质量评价两种评价标准的比较一、引言在医学领域,全血细胞计数是评估一个人健康状况的重要指标之一。
而为了确保全国各地不同医疗机构的血液检测结果的准确性和可比性,需要对全国全血细胞计数室间质量进行评价。
而在评价过程中,常常使用两种不同的评价标准,分别是XXX和YYY,本文将对这两种评价标准进行比较,以探讨它们的优劣势,为全国全血细胞计数室间质量的评价提供参考。
二、XXX评价标准的介绍XXX评价标准是由国家卫生健康委员会制定的,它主要从仪器校准、质量控制、现场质量评价和质量管理等方面对全国全血细胞计数室间质量进行评价。
该标准以其全面性和权威性而被广泛应用于全国各地医疗机构。
三、YYY评价标准的介绍而YYY评价标准则是由我国医学科学院制定的,它注重从实验室操作、仪器维护、质量管控和数据分析等方面对全国全血细胞计数室间质量进行评价。
该标准因其注重操作细节和实用性而备受医疗机构关注。
四、两种评价标准的比较1. 评价内容XXX评价标准包含的评价内容更为全面,从仪器校准到现场质量评价,涵盖了全面的质量评价要素。
而YYY评价标准注重实验室操作和数据分析,更侧重于实际操作流程。
2. 评价角度XXX评价标准更注重仪器的精准度和稳定性,以及现场环境的质量控制,从仪器和环境两个角度综合评价。
而YYY评价标准更注重实验室内部操作的规范性和数据分析的准确性,更侧重实验室内部的质量控制。
3. 适用范围XXX评价标准的适用范围更广,涵盖了各种类型的医疗机构和不同类型的仪器。
而YYY评价标准更适用于实验室内部工作流程,对于大型综合性医院的实验室质量评价效果更佳。
五、结论XXX评价标准和YYY评价标准各有其优势和劣势。
在实际应用中,需要根据医疗机构的具体情况来选择合适的评价标准,以确保全国全血细胞计数室间质量的准确性和可比性。
我个人认为,在选择评价标准时,应根据实际情况进行综合考量,既要注重全面性和权威性,也要注重操作性和实用性,以达到最佳的评价效果。


卫生部临床检验中心室间质量评价标准文件管理序列号:[K8UY-K9IO69-O6M243-OL889-F88688]2017年卫生部临床检验中心室间质量评价标准临床化学(NCCL-C-01)2017年2016年钾靶值±6%靶值±0.5mmol/L钠靶值±4%靶值±4mmol/L氯靶值±5%靶值±5%钙靶值±5%靶值±0.250mmol/L(1.0mg/dL)磷靶值±10%靶值±0.097mmol/L或靶值±10.7%(取大者)葡萄糖靶值±7%靶值±0.33mmol/L(6mg/dL)或±10%(取大者)尿素靶值±8%靶值±0.71mmol/L或±9%(取大者)尿酸靶值±12%靶值±17%肌酐靶值±12%靶值±26.5ummol/L(0.3mg/dL)或±15%(取大者)总蛋白靶值±5%靶值±10%白蛋白靶值±6%靶值±10%总胆固醇靶值±9%靶值±10%甘油三酯靶值±14%靶值±25%高密度脂蛋白胆固醇靶值±30%总胆红素靶值±15%靶值±6.84mmol/L(0.4mg/dL)或±20%(取大者)丙氨酸氨基转移酶靶值±16%靶值±20%天门冬氨酸氨基转移酶靶值±15%靶值±20%碱性磷酸酶靶值±18%靶值±30%淀粉酶靶值±15%靶值±30%肌酸激酶靶值±15%靶值±30%乳酸脱氢酶靶值±11%靶值±20%直接胆红素靶值±2s靶值±2s铁靶值±15%靶值±20%总铁结合力靶值±2s镁靶值±15%靶值±25%锂靶值±0.3mmol/L或±20%(取大者)铜靶值±2s锌靶值±2s酸性磷酸酶靶值±30%γ-谷氨酰基转移酶靶值±11%靶值±20%α-羟丁酸脱氢酶靶值±30%靶值±30%胆碱酯酶靶值±20%靶值±20%脂肪酶靶值±20%靶值±20%心肌标志物肌酸激酶-MB(ug/L)靶值±30%靶值±30%肌红蛋白靶值±30%靶值±30%肌钙蛋白-I靶值±30%靶值±30%肌钙蛋白-T靶值±30%靶值±30%肌酸激酶-MB(U/L)靶值±30%超敏CRP靶值±30%靶值±30%同型半胱氨酸靶值±2.5μmol/L或±20%(取大者)脂类胆固醇靶值±9%靶值±10%甘油三酯靶值±14%靶值±25%高密度脂蛋白胆固醇靶值±30%靶值±30%低密度脂蛋白胆固醇靶值±30%靶值±30%载脂蛋白A1靶值±30%靶值±30%载脂蛋白B靶值±30%靶值±30%脂蛋白(a)靶值±30%血气分析pH靶值±0.04靶值±0.04pCO2靶值±5mmHg或±8%(取大者)靶值±5mmHg或±8%(取大者)pO2靶值±8%靶值±2SNa+靶值±4%靶值±4mmol/LK+靶值±6%靶值±0.5mmol/LCa2+靶值±5%靶值±0.25mmol/LCl-靶值±4%靶值±5%特殊蛋白IgG、IgA、IgE、IgM、C3、C4、C-反应蛋白(CRP)、类风湿因子(RF)、抗链球菌溶血素O (ASO)、转铁蛋白(TRF)、前白蛋白(PA)靶值±25%靶值±25%内分泌总T4靶值±20%靶值±20%叶酸靶值±30%靶值±30%皮质醇、雌二醇、FSH、LH、孕酮、催乳素、睾酮、C-肽、FT3、TT3、FT4、胰岛素、维生素B12、25-OH-VD2、25-OH-VD3、总25-OH-VD靶值±25%靶值±25%肿瘤标志物CEA、AFP、HCG、PSA、CA199、CA125、CA153、β2-微球蛋白、铁蛋白、总β-HCG、游离PSA靶值±25%全血治疗药物监测环孢霉素A、他克莫司、西罗莫司靶值±25%血清治疗药物监测卡马西平靶值±25%地高辛靶值±20%或±0.2μg/L苯妥英靶值±25%茶碱靶值±25%丙戊酸靶值±25%糖化血红蛋白HbA1c靶值±8%脑钠肽/N末端前脑钠肽BNP、NT-proBNP靶值±30%尿液定量生化钾靶值±29%钠靶值±26%氯靶值±26%钙靶值±31%镁靶值±25%磷靶值±23%葡萄糖靶值±20%尿素靶值±21%尿酸靶值±24%肌酐靶值±17%总蛋白靶值±44%白蛋白靶值±30%淀粉酶靶值±30%微量白蛋白靶值±30%半胱氨酸蛋白酶抑制剂C半胱氨酸蛋白酶抑制剂C靶值±25%代谢物、总蛋白正确度验证葡萄糖靶值±3.5%尿素靶值±4.0%尿酸靶值±6%肌酐靶值±6%总蛋白靶值±2.8%脂类正确度验证总胆固醇靶值±4.5%甘油三酯靶值±7.5%高密度脂蛋白胆固醇靶值±6.5%酶学正确度验证ALT(含磷酸吡哆醛)靶值±6% AST(含磷酸吡哆醛)靶值±5%GGT靶值±5.5%LDH靶值±4%CK靶值±5.5%AMY靶值±7.5%ALP靶值±10%糖化血红蛋白正确度验证HbA1c靶值±6%电解质正确度验证钠靶值±1.5%钾靶值±2%钙靶值±2%镁靶值±5.5%一般免疫学抗核抗体反应性或阴性抗-HIV反应性或阴性肝炎(HBsAg,anti-HBc,HBeAg)反应性或阴性风疹反应性或阴性全血细胞计数白细胞计数靶值±15%红细胞计数靶值±6%血红蛋白测定靶值±6%血细胞比容靶值±9%血小板计数靶值±20%MCV靶值±7%MCH靶值±7%MCHC靶值±8%凝血试验PT靶值±15%INR靶值±20%APTT靶值±15%Fbg靶值±20%尿液化学分析比重靶值±1等级PH靶值±1等级蛋白、葡萄糖、胆红素、酮体、红细胞、尿胆原、白细胞阳性时:靶值±1等级亚硝酸盐阴性或阳性红细胞沉降率测定红细胞沉降率靶值±3.0(≤10时)或靶值±30%(>10时)流式细胞分析CD3+、CD3+CD4+、CD3+CD8+、CD3-CD16+CD56+、CD3-CD19+靶值±2s血液粘度检测切变率为1/S下的粘度(mPa.s)靶值±2s切变率为50/S下的粘度(mPa.s)靶值±2s切变率为200/S下的粘度(mPa.s)靶值±2s网织红细胞计数网织红细胞百分比(%)靶值±2s全血细胞计数正确度验证白细胞计数靶值±15%红细胞计数靶值±6%血红蛋白测定靶值±6%血细胞比容靶值±9%血小板计数靶值±20%MCV靶值±7%MCH靶值±7%MCHC靶值±8%凝血因子检测FⅧ、FⅨ靶值±30%D-二聚体检测D-Dimer靶值±2s新生儿遗传代谢病筛查-Phe、TSH苯丙氨酸靶值±30%或±1mg/dL(取大值)促甲状腺素靶值±30%中孕期母血清产前筛查AFP靶值±30%或±5μg/L(取大值)hCG靶值±30%β-hCG靶值±30%Free-β-hCG靶值±30%游离雌三醇靶值±30%血铅血铅靶值±40μg/L或±10%(取大值)便携式血糖检测仪葡萄糖靶值±20%或±1mmol/L(取大值)脑脊液生化白蛋白靶值±10%或±0.1g/L(取大值)总蛋白靶值±10%或±0.1g/L(取大值)氯化物靶值±5%葡萄糖靶值±10%或±1.0mmol/L(取大值)乳酸脱氢酶靶值±20%IgA靶值±25%IgG靶值±25%IgM靶值±25%乳酸靶值±20%或±0.1mmol/L(取大值)全血五元素铜靶值±2s锌靶值±2s钙靶值±0.25mmol/L镁靶值±25%铁靶值±20%新生儿遗传代谢病筛查-G6PDG6PD靶值±30%新生儿遗传代谢病筛查-17羟孕酮17-羟孕酮靶值±30%新生儿遗传代谢病串联质谱筛查-氨基酸和酰基肉碱瓜氨酸靶值±25%亮氨酸靶值±25%甲硫氨酸靶值±25%苯丙氨酸靶值±25%酪氨酸靶值±25%缬氨酸靶值±25%游离肉碱靶值±30%丙酰肉碱靶值±30%异戊酰肉碱靶值±30%辛酰肉碱靶值±30%月桂酰肉碱靶值±30%棕榈酰肉碱靶值±30%十八碳酰肉碱靶值±30%血红蛋白A2和血红蛋白F血红蛋白A2靶值±20%血红蛋白F靶值±20%早孕期母血清产前筛查PAPP-A(μg/L)靶值±30% PAPP-A(mU/L)靶值±30%Free-β-HCG(μg/L)靶值±30%Free-β-HCG(mIU/mL)靶值±30%。

实验室血液分析中的室间质评项目的质评结果-医学技术论文-基础医学论文-医学论文——文章均为WORD文档,下载后可直接编辑使用亦可打印——质量是检验科的生命,没有高质量的检验结果,就不能为临床提供可靠的诊断和治疗依据。
临床实验室的质量控制目标就是检测结果的及时、准确、可靠,为临床医师正确诊断和治疗疾病提供检验数据。
血液分析是临床检验中最常用的实验室检测项目,包括血细胞计数和形态学分析,影响因素众多。
目前,大部分临床实验室都有质量持续改进措施,但是在质量持续改进实施过程中缺乏一个有效的评价工具,特别是血常规检验在目前无法溯源的情况下更是缺乏可靠的评价标准,只有严格控制每一步才会尽可能地让检测结果与疾病病程高度相关[1-2].现将该实验室血液分析中的室间质评项目(全血细胞计数、网织红细胞计数、细胞形态学)的质评结果,现将结果报道如下。
1资料与方法1.1一般资料全血细胞计数和网织红细胞计数室间质评,外周血及骨髓涂片的彩图,并附以细胞的染色方法及相关结果选项的代码。
1.2仪器与试剂日本Sysmex XT2000i/XE-2100全自动五分类血液细胞分析仪,使用配套校准品。
每年对该科室所有血细胞分析仪进行校准2次,性能评价1次,每日至少完成1次室内质控,保证仪器的精密度。
所有试剂均为原装配套。
1.3质评物由卫生部临床检验中心和重庆市临床检验中心提供。
1.4方法1.4.1收到质控全血后按要求恢复室温、混匀,与临床样品同样的检测方式对每个批号质评物进行测定,检测结果按要求及时上报,由卫生部或重庆市临床检验中心统计、计算成绩。
全血细胞计数项目,临床检验中心每次测评物分为5个批号,每年2次,其中卫生部临床检验中心每个批号分别做8个项目,即白细胞(WBC)、红细胞(RBC)、血红蛋白(Hgb)、红细胞压积(HCT)、血小板计数(PLT)、平均红细胞体积(MCV)、平均血红蛋白含量(MCH)、平均血红蛋白浓度(MCHC),重庆市临床检验中心每个批号分别做4个项目(WBC、RBC、Hgb、PLT)。

2017年卫生部临床检验中心室间质量评价标准临床化学(NCCL-C-01)2017年2016年钾靶值±6%靶值±0.5mmol/L钠靶值±4%靶值±4mmol/L氯靶值±5%靶值±5%钙靶值±5%靶值±0.250mmol/L(1.0mg/dL)磷靶值±10%靶值±0.097mmol/L或靶值±10.7%(取大者)葡萄糖靶值±7%靶值±0.33mmol/L(6mg/dL)或±10%(取大者)尿素靶值±8%靶值±0.71mmol/L或±9%(取大者)尿酸靶值±12%靶值±17%肌酐靶值±12%靶值±26.5ummol/L(0.3mg/dL)或±15%(取大者)总蛋白靶值±5%靶值±10%白蛋白靶值±6%靶值±10%总胆固醇靶值±9%靶值±10%甘油三酯靶值±14%靶值±25%高密度脂蛋白胆固醇靶值±30%总胆红素靶值±15%靶值±6.84mmol/L(0.4mg/dL)或±20%(取大者)丙氨酸氨基转移酶靶值±16%靶值±20%天门冬氨酸氨基转移酶靶值±15%靶值±20%碱性磷酸酶靶值±18%靶值±30%淀粉酶靶值±15%靶值±30%肌酸激酶靶值±15%靶值±30%乳酸脱氢酶靶值±11%靶值±20%直接胆红素靶值±2s靶值±2s铁靶值±15%靶值±20%总铁结合力靶值±2s镁靶值±15%靶值±25%锂靶值±0.3mmol/L或±20%(取大者)铜靶值±2s锌靶值±2s酸性磷酸酶靶值±30%γ-谷氨酰基转移酶靶值±11%靶值±20%α-羟丁酸脱氢酶靶值±30%靶值±30%胆碱酯酶靶值±20%靶值±20%脂肪酶靶值±20%靶值±20%心肌标志物肌酸激酶-MB(ug/L)靶值±30%靶值±30%肌红蛋白靶值±30%靶值±30%肌钙蛋白-I靶值±30%靶值±30%肌钙蛋白-T靶值±30%靶值±30%肌酸激酶-MB(U/L)靶值±30%超敏CRP靶值±30%靶值±30%同型半胱氨酸靶值±2.5μmol/L或±20%(取大者)脂类胆固醇靶值±9%靶值±10%甘油三酯靶值±14%靶值±25%高密度脂蛋白胆固醇靶值±30%靶值±30%低密度脂蛋白胆固醇靶值±30%靶值±30%载脂蛋白A1靶值±30%靶值±30%载脂蛋白B靶值±30%靶值±30%脂蛋白(a)靶值±30%血气分析pH靶值±0.04靶值±0.04pCO2靶值±5mmHg或±8%(取大者)靶值±5mmHg或±8%(取大者)pO2靶值±8%靶值±2SNa+靶值±4%靶值±4mmol/LK+靶值±6%靶值±0.5mmol/LCa2+靶值±5%靶值±0.25mmol/LCl-靶值±4%靶值±5%特殊蛋白IgG、IgA、IgE、IgM、C3、C4、C-反应蛋白(CRP)、类风湿因子(RF)、抗链球菌溶血素O (ASO)、转铁蛋白(TRF)、前白蛋白(PA)靶值±25%靶值±25%内分泌总T4靶值±20%靶值±20%叶酸靶值±30%靶值±30%皮质醇、雌二醇、FSH、LH、孕酮、催乳素、睾酮、C-肽、FT3、TT3、FT4、胰岛素、维生素B12、25-OH-VD2、25-OH-VD3、总25-OH-VD靶值±25%靶值±25%肿瘤标志物CEA、AFP、HCG、PSA、CA199、CA125、CA153、β2-微球蛋白、铁蛋白、总β-HCG、游离PSA靶值±25%全血治疗药物监测环孢霉素A、他克莫司、西罗莫司靶值±25%血清治疗药物监测卡马西平靶值±25%地高辛靶值±20%或±0.2μg/L苯妥英靶值±25%茶碱靶值±25%丙戊酸靶值±25%糖化血红蛋白HbA1c靶值±8%脑钠肽/N末端前脑钠肽BNP、NT-proBNP靶值±30%尿液定量生化钾靶值±29%钠靶值±26%氯靶值±26%钙靶值±31%镁靶值±25%磷靶值±23%葡萄糖靶值±20%尿酸靶值±24%肌酐靶值±17%总蛋白靶值±44%白蛋白靶值±30%淀粉酶靶值±30%微量白蛋白靶值±30%半胱氨酸蛋白酶抑制剂C半胱氨酸蛋白酶抑制剂C靶值±25%代谢物、总蛋白正确度验证葡萄糖靶值±3.5%尿素靶值±4.0%尿酸靶值±6%肌酐靶值±6%总蛋白靶值±2.8%脂类正确度验证总胆固醇靶值±4.5%甘油三酯靶值±7.5%高密度脂蛋白胆固醇靶值±6.5%酶学正确度验证ALT(含磷酸吡哆醛)靶值±6%AST(含磷酸吡哆醛)靶值±5%GGT靶值±5.5%LDH靶值±4%CK靶值±5.5%ALP靶值±10%糖化血红蛋白正确度验证HbA1c靶值±6%电解质正确度验证钠靶值±1.5%钾靶值±2%钙靶值±2%镁靶值±5.5%一般免疫学抗核抗体反应性或阴性抗-HIV反应性或阴性肝炎(HBsAg,anti-HBc,HBeAg)反应性或阴性风疹反应性或阴性全血细胞计数白细胞计数靶值±15%红细胞计数靶值±6%血红蛋白测定靶值±6%血细胞比容靶值±9%血小板计数靶值±20%MCV靶值±7%MCH靶值±7%MCHC靶值±8%凝血试验PT靶值±15%INR靶值±20%APTT靶值±15%Fbg靶值±20%尿液化学分析比重靶值±1等级PH靶值±1等级蛋白、葡萄糖、胆红素、酮体、红细胞、尿胆原、白细胞阳性时:靶值±1等级亚硝酸盐阴性或阳性红细胞沉降率测定红细胞沉降率靶值±3.0(≤10时)或靶值±30%(>10时)流式细胞分析CD3+、CD3+CD4+、CD3+CD8+、CD3-CD16+CD56+、CD3-CD19+靶值±2s血液粘度检测切变率为1/S下的粘度(mPa.s)靶值±2s切变率为50/S下的粘度(mPa.s)靶值±2s切变率为200/S下的粘度(mPa.s)靶值±2s网织红细胞计数网织红细胞百分比(%)靶值±2s全血细胞计数正确度验证白细胞计数靶值±15%红细胞计数靶值±6%血红蛋白测定靶值±6%血细胞比容靶值±9%血小板计数靶值±20%MCV靶值±7%MCH靶值±7%MCHC靶值±8%凝血因子检测FⅧ、FⅨ靶值±30%D-二聚体检测D-Dimer靶值±2s新生儿遗传代谢病筛查-Phe、TSH苯丙氨酸靶值±30%或±1mg/dL(取大值)促甲状腺素靶值±30%中孕期母血清产前筛查AFP靶值±30%或±5μg/L(取大值)hCG靶值±30%β-hCG靶值±30%Free-β-hCG靶值±30%游离雌三醇靶值±30%血铅血铅靶值±40μg/L或±10%(取大值)便携式血糖检测仪葡萄糖靶值±20%或±1mmol/L(取大值)脑脊液生化白蛋白靶值±10%或±0.1g/L(取大值)总蛋白靶值±10%或±0.1g/L(取大值)氯化物靶值±5%葡萄糖靶值±10%或±1.0mmol/L(取大值)乳酸脱氢酶靶值±20%IgA靶值±25%IgG靶值±25%IgM靶值±25%乳酸靶值±20%或±0.1mmol/L(取大值)全血五元素铜靶值±2s锌靶值±2s钙靶值±0.25mmol/L镁靶值±25%铁靶值±20%新生儿遗传代谢病筛查-G6PDG6PD靶值±30%新生儿遗传代谢病筛查-17羟孕酮17-羟孕酮靶值±30% 新生儿遗传代谢病串联质谱筛查-氨基酸和酰基肉碱瓜氨酸靶值±25%亮氨酸靶值±25%甲硫氨酸靶值±25%苯丙氨酸靶值±25%酪氨酸靶值±25%缬氨酸靶值±25%游离肉碱靶值±30%丙酰肉碱靶值±30%异戊酰肉碱靶值±30%辛酰肉碱靶值±30%月桂酰肉碱靶值±30%棕榈酰肉碱靶值±30%十八碳酰肉碱靶值±30%血红蛋白A2和血红蛋白F血红蛋白A2靶值±20%血红蛋白F靶值±20%早孕期母血清产前筛查PAPP-A(μg/L)靶值±30% PAPP-A(mU/L)靶值±30%Free-β-HCG(μg/L)靶值±30%Free-β-HCG(mIU/mL)靶值±30%。

2009年~2013年全国血细胞形态学室间质评小结作者:李明芬韦巍林英辉韦常丽来源:《医学信息》2014年第21期摘要:目的回顾性分析广西中医药大学第一附属医院2009~2013年间全国卫生部血细胞形态室间质评结果及错报比例,提高检验人员辩识细胞形态的能力。
方法对卫生部临检中心5年间发放的血细胞形态室间质评图片共150幅彩图进行辨认,待结果回报后进行统计分析。
结果 5年15次共150幅血细胞形态室间质评回报结果中,错报共17幅,错报率为11.3%,其中以2010年~2011年错报率最高为16.7%。
结论通过开展血细胞形态室间质评,对质评结果进行反馈,分析错报原因,一方面开拓实验室技术人员的视野,丰富其知识,另一方面促进检验人员相互学习,提高其实验室对形态学的重视。
关键词:血细胞;形态学;室间质评;错报原因血细胞形态检查是每位检验技术人员必须掌握的基本技能之一,对疾病的诊断尤其是血液病的鉴别诊断极其重要,如何提高检验人员对细胞的辩识能力已成为每个实验室迫切需要解决的问题。
卫生部血细胞形态室间质评活动从1999年开始至今已有15年,该活动一方面有利于了解实验室对血细胞形态学的检验水平及质量,另一方面通过对质评结果反馈,分析错报原因,有利于进一步提高检验人员对各类细胞的认识,促进检验人员的学习能力。
1 资料与方法1.1一般资料卫生部临检中心发放的血细胞形态室间质评图片,5年间共150幅彩图。
1.2方法实验室2位技术人员对彩图认真辩识,统一结果后进行上报。
结果以相应的编码表示,以网上报告方式,待结果回报后,对结果进行统计分析。
2 结果5年15次共150幅血细胞形态室间质评回报结果中,错报共17幅,错报率为11.3%,符合率为88.7%,其中以2010年~2011年错报率最高为16.7%。
见表1,表2。
3 讨论血细胞形态室间质评不同于临床免疫学及临床生化学,通常临床免疫学及临床生化学通过统一发放液体或干粉质控品在实验室相应仪器进行测量,各实验室检查结果经过汇总后得出较客观的室间质评结果。
凝血试验室间质评结果回顾分析与总结高兴;张云【摘要】回顾性分析2011~2015年参加国家卫计委临检中心凝血试验室间质评活动结果,统计得分情况、偏倚变化趋势,分析所参加项目潜在的不符合趋势,了解实验室凝血试验检验质量水平,为提高质量管理水平奠定基础。
【期刊名称】《检验医学与临床》【年(卷),期】2016(013)020【总页数】2页(P2980-2981)【关键词】凝血试验;凝血酶原时间;国际标准化比值;活化部分凝血活酶时间;纤维蛋白原;室间质评【作者】高兴;张云【作者单位】中国人民解放军海军总医院检验科,北京100048;中国人民解放军海军总医院检验科,北京100048【正文语种】中文教学·管理室间质量评价(简称室间质评)又称能力验证或外部质量评价(EQA),是多家实验室分析同一标本,并由外部独立机构收集和反馈实验室上报结果,以此评价实验室检测质量水平的过程,有助于判断实验室校准、检测能力,并监控其持续改进的能力。
国家卫计委临检中心开展的凝血试验室间质评项目包括凝血酶原时间(PT)、国际标准化比值(INR)、活化部分凝血活酶时间(APTT)和纤维蛋白原(Fbg)。
本科室自2011年开始参加卫计委临检中心凝血试验室间质评活动。
笔者结合实际工作经验,以及2011~2015年室间质评结果,分析了临床工作中可能存在的问题,旨在推动凝血试验项目检验质量的不断提高。
1.1 标本来源卫计委临检中心发放的质控标本,每年2次,每次5个标本。
1.2 仪器与试剂美国贝克曼库尔特公司ACL TOP 700型全自动血凝仪及配套质控品、检测试剂。
1.3 方法1.3.1 检测方法按卫计委临检中心规定的时间和要求,在检测患者标本的同时进行质控标本检测。
检测方法参照《全国临床检验操作规程》[1]。
每批质控物连续检测5次,计算均值。
INR=PTRISI,ISI为国际敏感指数,PTR为PT检测结果与PT标准对照值的比值。
卫生部临床检验中心
2007 年第1 次血细胞形态学检查室间质量评价
卫生部临床检验中心
2007 年第2 次血细胞形态学检查室间质量评价
卫生部临床检验中心
2007 年第3 次血细胞形态学检查室间质量评价
卫生部临床检验中心
2008 年第1 次血细胞形态学检查室间质量评价
卫生部临床检验中心
2008 年第2 次血细胞形态学检查室间质量评价
卫生部临床检验中心
2008 年第3 次血细胞形态学检查室间质量评价
卫生部临床检验中心
2009 年第1 次血细胞形态学检查室间质量评价
卫生部临床检验中心
2009 年第2 次血细胞形态学检查室间质量评价
卫生部临床检验中心
2009 年第3 次血细胞形态学检查室间质量评价
卫生部临床检验中心
2010 年第1 次血细胞形态学检查室间质量评价
卫生部临床检验中心
2010 年第2 次血细胞形态学检查室间质量评价
卫生部临床检验中心
2010 年第3 次血细胞形态学检查室间质量评价
卫生部临床检验中心
2011 年第1 次血细胞形态学检查室间质量评价
卫生部临床检验中心
2011 年第2 次血细胞形态学检查室间质量评价
图片
卫生部临床检验中心
2011 年第3 次血细胞形态学检查室间质量评价
卫生部临床检验中心
2012 年第1 次血细胞形态学检查室间质量评价
卫生部临床检验中心
2012 年第2 次血细胞形态学检查室间质量评价。